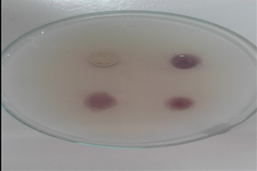
Antibacterial activity of Lanata camara extract

- Visibility 730 Views
- Downloads 98 Downloads
- Permissions
- DOI 10.18231/j.ijpca.2021.033
-
CrossMark
- Citation
Phytochemical analysis and antimicrobial activity of Lantana camara
- Author Details:
-
Vishal H. Thorat
-
Firoj A. Tamboli *
-
Asha S. Jadhav
-
Rohankumar Chavan
Abstract
Background: Lantana camara, Family: Verbenaceae has been an important coniferous plant in ayurvedic and indigenous medicinal systems. The Clinical trials and animal research support the use of Lantana camara for anti-spasmodic, carminative, anti-tumor, anti-inflammatory, anti-malarial, anti-ulcer genic, treatment of emotional stress and trauma, anti-microbial, insecticidal, fungicidal, and asthma.
Materials and Methods: The present study was planned for extraction, phytochemical analysis, powder characteristics and the antimicrobial activity of the of Lantana camara crude extract.
Result and Conclusion: Phytochemical analysis showed presence of various secondary metabolites like alkaloids, saponins, tannins, glycosides and terpenoids. Antibacterial activity of Lantana camara against Staphylococcus aureus showed positive results.
Introduction
Lantana camara (common lantana) is a species of flowering plant within the verbena family (Verbenaceae), native to the American tropics. Other common names of Lantana camara include big-sage(Malaysia), wild-sage, red-sage, white-sage (Caribbean), tickberry (South Africa), West Indian lantana and umbelanterna.[1], [2] As an ornamental, Lantana camara is often cultivated indoors, or in a conservatory, but can also thrive in a garden with sufficient shelter.
Flowers come in many different colours, including red, yellow, white, pink and orange, which differ depending on location in inflorescences, age, and maturity. The flower has a tutti-frutti smell with a peppery undertone. After pollination occurs the colour of the flowers changes (typically from yellow to orangish, pinkish, or reddish); this is believed to be a signal to pollinators that the pre-change colour contains a reward as well as being sexually viable, thus increasing pollination efficiency. The leaves are broadly ovate, opposite, and simple and have a strong odour when crushed. The fruit of Lantana camara is a berry-like drupe which turns from green to dark purple when mature. Green unripe fruits are inedible to humans and animals alike.Because of dense patches of hard spikes on their rind, ingestion of them can result in serious damage to the digestive tract. Both vegetative (asexual) and seed reproduction occur. Up to 12,000 fruits canbe produced by each plant which are then eaten by birds and other animals which can spread the seeds over large distances, facilitating the spread of Lantana camara.[3] It has become a significant weed in Sri Lanka after escaping from the Royal Botanic gardens in 1926.[4], [5] In contrast, in countries with large areas of intact primary forest, the distribution of Lantana camara has been limited[6]
Phytochemical investigation of Lantana camara showed the presences of flavones, isoflavones, flavonoids, anthocyanins, coumarins, lignans, catechins, isocatechins, alkaloids, tannin, saponins and triterpenoids[7], [8], [9], [10]
The aim of the present study was to carry out the phytochemical screening and antibacterial activities of Lantana camara plant extracts.
Materials and Methods
Plant collection
The collected fresh plants of Lanata camara from Kolhapur region were washed with tap water, air- dried at room temperature for 2-3 weeks at 35-40oC and then reduced to coarse powder.
Extract preparation
Collected plant material was dried in shade and grounded in a grinder. The dried and powdered plant material was extracted successively with methanol using maceration extraction (as20 gm in 100 Ml) for 48h at a temperature not exceeding the boiling point of the solvent. The aqueous extracts were filtered using Whatman filter paper.[11]
Phytochemical screening
All the extracts were screened qualitatively for detection of phytoconstituents using general and specific chemical reagents.[12]
Evaluation of antibacterial activity
In vitro antimicrobial activity of Lantana camara against Staphylococcus aureus, E. coli & Pseudomonas aeruginosa was tested by preparing the Petri plate containing the nutrient agar as culture media and then spread the bacteria on nutria agar media, that Each concentration was poured by making the veals into Petri plates. Three replicates were made for each treatment. Then zone of inhibition around the application point was measured after 24hrs.[12]
Culture media
Nutrient agar, Nutrient broth were used throughout the study. The plant material was cleaned and decontaminated with ethylene oxide and irradiated.[12]
Micro-organisms used
Escherichia coli, Staphylococcus aureus, and Pseudomonas aeruginosa
Results
All the extracts were screened qualitatively for detection of phytoconstituents using general and specific chemical reagents as per the following
|
Sr. No. |
Phytochemical tests |
Lanata camara leaves |
|
1 |
Tannins |
+ve |
|
2 |
Phlobtannins |
-ve |
|
3 |
Saponins |
+ve |
|
4 |
Flavonoid |
-ve |
|
5 |
Terpenoid |
+ve |
|
6 |
Glycoside |
+ve |
|
7 |
Alkaloid |
+ve |
|
8 |
coumarin |
-ve |

|
Part used |
Stomatal No. |
Epidermal cell |
Stomatal index |
|
Epidermis |
22 |
55 |
28.27 |
|
19 |
62 |
23.45 |
|
|
24 |
61 |
28.23 |
|
|
23 |
57 |
28.75 |
|
|
17 |
52 |
24.63 |
|
Test organisms |
Zone of inhibition (mm) |
|
Escherichia coli |
18 |
|
Pseudomonas aeruginosa |
16 |
|
Staphylococcus aureus |
19 |
Discussion
The leaf surface constants such as stomatal index for upper epidermis was found important diagnostic characters. The antimicrobial activity may be due to the presence of triterpene secondary metabolite in the extract. Therefore, in this project by the use of solvent-extracted leaves extracts of Lantana camara containing a highly potential phytochemical which could be characterized and thus, find its way into the arsenal of lucrative antimicrobial drugs study.
Conclusion
The phytochemical analysis of Lantana camara extracts showed the presence of different secondary metabolites, like alkaloids, phenols, flavonoids, glycosides, tannins and terpenoids.presence of these compounds might be responsible for its antimicrobial activity. The study showed that the solvent extracts investigated were active against various Gram positive and Gram negative bacteria Alcoholic extract of Lantana camera leaves exhibited stronger antimicrobial activity. Among the set of test bacterial strains alcoholic extract of the test plant inhibited the growth of Staphylococcus aureus to the maximum.
Source of Funding
None.
Conflict of Interest
None.
References
- Ghisalberti EL, Camara LL. Lantana camara L. (Verbenaceae). Fitoterapia. 2000;71(5):467-86. [Google Scholar] [Crossref]
- Thakur ML, Ahmad M, Thakur RK. Lantana weed (Lantana camara var. aculeata Linn) and its possible management through natural insect pests in India. Indian Forester. 1992;118(7):466-88. [Google Scholar]
- Zoubiri S, Baaliouamer A. GC and GC/MS analyses of the Algerian Lantana camara leaf essential oil: Effect against Sitophilus granarius adults. J Saudi Chem Soc. 2011;16(3):291-7. [Google Scholar] [Crossref]
- Bevilacqua AHV, Suffredini IB, Romoff P, Lago JHG, Bernardi M. Toxicity of apolar and Polar Lantana camara L. crude extracts in mice. Rese Vet Sci. 2011;90(1):106-15. [Google Scholar] [Crossref]
- Ramzi SC, Vinay K, Stanley R. Robbins pathologic basis of disease.. . 1994. [Google Scholar]
- Sam D, Khan S. Biochemical compositions and antibacterial activities of Lantana camara plants with yellow lavender, red and white flowers. Eurasia J Biol Sci. 2009;3:69-77. [Google Scholar] [Crossref]
- Saraf A, Quereshi S, Sharma K, Khan NA. Antimicrobial activity of Lantana camara L. Indian J Exp Sci. 2011;2(10):50-4. [Google Scholar]
- Singh P, Srivastava D. Biofungicides or biocontrol activity of Lantana camara against phytopathogenic Alternaira alternata. Int J Pharm Sci Res. 2012;3(12):4818-21. [Google Scholar]
- Jancyrani J, Chandramohan G, Ravikumar S. Terpenes and antimicrobial activity from Lantana camara leaves. Res J Recent Sci. 2014;3(9):52-5. [Google Scholar]
- Tamboli AF, More HN. Evaluation of Anti ulcer and Antioxidant activity of Barleria gibsoni Dalz. . Pharmacogn Res. 2016;8(4):226-30. [Google Scholar] [Crossref]
- Tamboli FA, More H. Pharmacognostic and Physicochemical analysis of Barleria gibsoni Dalz. Pharmacophore. 2016;7(2):118-23. [Google Scholar]
- Hedberg I, Hedberg O, Madati PJ, Mshigeni KE, Mshiu EN, Samuelsson G. Inventory of plants used in traditional medicine in tanzania. Part III. Plants of the families papilionaceaevitaceae. J Ethnopharmacol. 1983;9(2):237-60. [Google Scholar] [Crossref]
How to Cite This Article
Vancouver
Thorat VH, Tamboli FA, Jadhav AS, Chavan R. Phytochemical analysis and antimicrobial activity of Lantana camara [Internet]. Int J Pharm Chem Anal. 2021 [cited 2025 Nov 04];8(4):171-173. Available from: https://doi.org/10.18231/j.ijpca.2021.033
APA
Thorat, V. H., Tamboli, F. A., Jadhav, A. S., Chavan, R. (2021). Phytochemical analysis and antimicrobial activity of Lantana camara. Int J Pharm Chem Anal, 8(4), 171-173. https://doi.org/10.18231/j.ijpca.2021.033
MLA
Thorat, Vishal H., Tamboli, Firoj A., Jadhav, Asha S., Chavan, Rohankumar. "Phytochemical analysis and antimicrobial activity of Lantana camara." Int J Pharm Chem Anal, vol. 8, no. 4, 2021, pp. 171-173. https://doi.org/10.18231/j.ijpca.2021.033
Chicago
Thorat, V. H., Tamboli, F. A., Jadhav, A. S., Chavan, R.. "Phytochemical analysis and antimicrobial activity of Lantana camara." Int J Pharm Chem Anal 8, no. 4 (2021): 171-173. https://doi.org/10.18231/j.ijpca.2021.033
